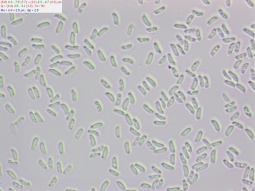

Peniophora rufa
Полное научное имя: Peniophora rufa (Fr.) Boidin
Другие названия: Sterellum rufum (Fr.) J. Erikss.
Систематика: Fungi&Protozoa => Fungi => Basidiomycota => Agaricomycotina => Agaricomycetes => Incertae sedis => Russulales => Peniophoraceae => Peniophora